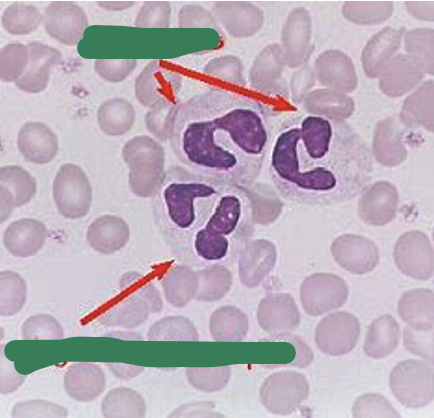
term image
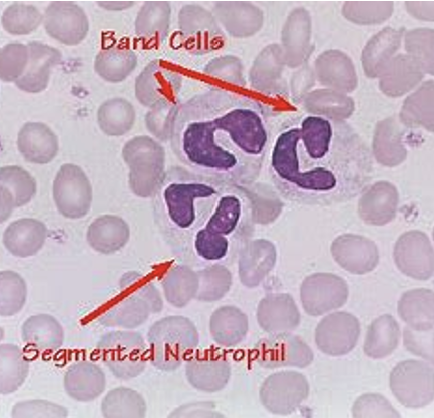
<p><span style="font-family: "Calibri Light";"><span>Neutrophil types: </span></span></p><ul><li><p><span style="font-family: "Calibri Light";"><span>bands (immature) </span></span></p></li><li><p><span style="font-family: "Calibri Light";"><span>segmented (mature)</span></span></p></li></ul><p></p>
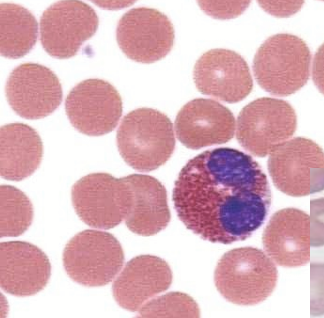
term image

Ch 2, write question
1/37
There's no tags or description
Looks like no tags are added yet.
Name | Mastery | Learn | Test | Matching | Spaced | Call with Kai |
|---|
No study sessions yet.
38 Terms
Student Learning Outcomes:
Define hematology and list 4 reasons for performing hematology tests.
Differentiate between: whole blood, serum and plasma specimens.
Name at least 4 critical areas which contribute to the quality of blood samples.
Describe the various types of evacuated tubes and the significance of the different stopper colors, thixotropic gel, & the expiration date.
List the 4 blood tubes usually drawn as the “Rainbow” on Emergency Department patients, the additives contained inside, and whether the additive is an anticoagulant.
Describe the specimen requirement for most hematology tests and the storage requirements for CBC, blood smear & ESR.
Describe the 5 pieces of information which must be on every blood specimen label and identify correctly labeled tubes.
List at least 5 factors which affect specimen quality.
Differentiate between RBC’s, PLT’s, and the 5 types of white blood cells.
What is Hematology the study of?
What are alterations (changes) in blood components usually a result of?
What are changes in blood components often the first sign of?
What do Hematology tests and any other lab tests help confirm?
Hematology is the study of blood cells and their related disorders (problems).
Alterations (changes) in the blood components are usually a result of disease rather than being the primary (main) cause of disease.
Changes in blood components are often the first sign that disease is occurring (happening) in the body.
Hematology tests are used to:
Confirm what the provider suspects.
Detect (find) an unsuspected disorder (problem you didn’t know about).
Diagnose (identify) or rule out diseases.
Track how treatments (meds, radiation, chemo) are working.
How are reference ranges (normal values) for a group of people determined?
What is the reference range reported as, in relation to the mean?
Which blood cell measurements have reference ranges that differ by age, sex, and pregnancy?
Each lab must create its own ranges based off of what?
Reference Ranges aka Normal Values:
For a group of people (newborns, pediatric (children), adult, geriatric (elderly), etc.) these reference ranges are determined by calculating the mean (average) for healthy individuals of the group
The Reference Range is than reported as the mean ± 2 standard deviations (SD).
Reference Ranges for several RBC parameters (red blood cell measurements) are different for different age groups and sexes, as well as during pregnancy.
Each lab must create its own ranges based on its patients, testing methods, and equipment
What percentage of human blood is liquid (plasma/serum)?
What percentage of human blood is made of cells (RBCs, WBCs, PLTs)?
What chemical must be present to prevent blood from clotting outside the body?
When centrifuging, what are the 3 parts obtained when using an anti-coagulant?
Human Blood = ~55% liquid (plasma/serum) + ~45% cells (RBCs, WBCs, PLTs).
If blood has an anticoagulant (a chemical that prevents clotting), it separates in 30 min:
Plasma on top (the liquid part).
WBCs & PLTs in the middle (called the “buffy coat”)
WBCs (white blood cells)
PLTs (platelets)
RBCs on the bottom (heaviest)
list the 2 categories for white blood cells and what they further divide into
White blood cells includes
agranulocytes:
Lymphocytes
monocytes
Granulocytes:
Basophils
Neutrophils
Eosinophils
How does blood exist inside the body, and does it normally clot?
What happens to blood outside the body if no anticoagulant is added?
What is the liquid portion called when blood is drawn into an anticoagulated tube?
What is the liquid portion called when blood is allowed to clot?
Blood exists inside the body as whole blood (all components together) and normally does not clot.
Outside the body, blood clots unless an anticoagulant (a chemical that prevents clotting) is added.
After collection, when blood settles or is centrifuged, it separates into liquid on top and cells on the bottom.
Plasma = liquid portion of blood from anti-coagulated tubes (tubes that prevent clotting).
Serum = liquid portion of blood that has been allowed to clot (as blood naturally does outside the body).
None of the clotting proteins exist in serum, because they are all used up
Plasma vs serum
Which one does not have fibrinogen since it is used up?
plasma
prevent clotting, has anti-coagulation
Serum
This is after coagulation (clotting)
Does not have fibrinogen since it is used up
serum= plasma -fibrinogen
What does the liquid portion of blood transport throughout the body?
What does the liquid portion of blood transport throughout the body?
What does the liquid portion of blood transport throughout the body?
What form do some proteins circulate in the blood?
When are inactive enzymes in the blood activated?
Which tube color is used for coagulation testing?
Blood cells have to be in what in order for us to count/identify them?
The Liquid Portion of blood is responsible for transporting (carrying/moving) nutrients and metabolites (substances the body makes or breaks down) within the system, such as carbohydrates (sugars), proteins, and lipids (fats).
For example, hormones made in one tissue are transported by the plasma to other areas of the body
The Clinical Chemistry section of the Lab tests for all of these chemical components:
proteins, carbohydrates (sugars), lipids (fats), electrolytes (charged minerals), minerals, and the gases oxygen & carbon dioxide.
The Liquid Portion also contains immune defense components such as Immunoglobulins (antibodies) and Complement (proteins that help destroy germs).
The Immunology & Immunohematology sections of the Lab test for these blood components.
Some proteins circulate (move around) in the blood as inactive enzymes (enzymes that are “turned off”) that only are activated during an injury so clotting can start
Coagulation test (blue tube) clotting time and anything to do with clotting
Blood cells must be in anticoagulant (non-clotting) tubes to be counted/identified; clotted cells cannot be counted.
Whole blood
plasma
Serum
Whole blood = Blood drawn in a tube with anticoagulant (chemical that prevents clotting).
No further processing is performed, because the entire well‑mixed sample is used for testing.
EX: Complete Blood Count (CBC) — lavender top tube containing EDTA (a chemical that prevents clotting).
Plasma = Supernatant (top liquid) portion of blood drawn in an anticoagulated tube (tube with chemical that prevents clotting) that is then centrifuged
The plasma is used for testing.
EX:
Coagulation tests: light blue top tube with sodium citrate (anti-coagulant).
STAT Chemistry tests: green top tube with heparin (anticoagulant).
Serum = Supernatant (top liquid) portion of blood drawn in a tube with NO anticoagulant, this clots
Red top or SST/gold top tubes contain a clot activator (such as thrombin, a chemical that speeds up clotting).
Blood is allowed to clot and then centrifuged. The serum is used for testing.
Why is obtaining the correct, high‑quality blood sample so important?
Where does the accuracy of lab testing begin?
Why are phlebotomists considered the lab ambassadors (representatives)?
Obtaining the correct, high quality blood sample is of utmost importance to give quality lab testing & results
The accuracy of lab testing begins with the quality of the specimen received by the laboratory
quality= how good is it, which depends on how the specimen was collected, transported and processed
Phlebotomists are the lab ambassadors (representatives).
The professional image (how the lab is viewed) is solely represented (shown) by the phlebotomist, because they are the only lab staff the patient sees and interacts with (talks to).
Even other healthcare staff often only see and talk with the phlebotomist or the lab assistant who answers the phone.
Why must MLT and CLS students know many details about specimen collection tubes?
Since the Hematology & Coagulation testing section staff must evaluate the quality of the specimen collected, MLT & CLS students must know many details about the specimen collection tubes/vacutainer tubes.
What is inside an additive tube?
What does an anticoagulant do in a blood collection tube?
What does thrombin do in a blood collection tube?
Which additive does Hematology use in its tubes?
Which additive does Coagulation use in its tubes?
What is inside a nonadditive tube?
What color stopper is usually found on nonadditive tubes?
What type of gel is found in SST and PST tubes?
What two portions does the gel separate during centrifugation?
Can SST and PST tubes be used for Hematology or Coagulation tests?
Additive tubes: a substance (chemical added to the tube) is inside the tube
For example, an anticoagulant (chemical that prevents clotting) or thrombin (chemical that speeds up clotting).
Hematology has Ethylene-di-amine-tetra-acetic acid (EDTA) and Coagulation as sodium citrate
Nonadditive tubes: no substance is added to the tube (empty tube).
These are rarely used and usually have a red stopper.
Thixotropic gel:
SST (serum separator tube) and PST (plasma separator tube) contain a thixotropic gel at the bottom.
During centrifugation (spinning at high speed), this gel migrates (moves) to form a barrier that separates the blood cells from the liquid portion.
These tubes cannot be used for any Hematology or Coagulation tests.
What are anticoagulants?
What are the two methods by which anticoagulants prevent clotting?
What does precipitating calcium mean in terms of preventing clotting?
Which anticoagulants work by removing or binding calcium?
What does inhibiting the formation of thrombin do?
Which anticoagulant works by stopping the body from making thrombin?
How many times must additive tubes be mixed by inversion after collection?
Anticoagulants = Substances (chemicals) that prevent blood from clotting.
There are two methods of preventing clotting:
Precipitating calcium (removing calcium so clotting can’t happen) by either binding aka chelating (grabbing and holding the calcium).
Examples: EDTA, sodium Citrates, Oxalates.Inhibiting formation of thrombin (stopping the body from making thrombin, a key clotting enzyme).
Example: lithium heparin and sodium heparin Heparin
Additive tubes must be mixed by inversion (gentle flipping) 5–10 times to spread the anticoagulant evenly through the specimen immediately after collection.
It is best to mix all tubes, because tubes with a clot activator also need mixing to work properly.
Why must anticoagulant tubes be mixed gently?
What does hemolysis mean?
What action should never be done when mixing tubes?
Mix anticoagulant tubes right away so they don’t clot.
Mix gently to avoid hemolysis (RBCs breaking).
Never shake — shaking causes hemolysis.
What tube contains anti-coagulant
Should we transfer blood from one tube to another?
Tube color tells you what additive is inside.
blue, Purple, green, grey = all contain anticoagulants.
Never transfer blood from one tube to another!
What is a rainbow draw?
what tubes are in the rainbow draws?
“Rainbow” draw – In the Emergency Department (ED), 4 tubes are drawn on a patient before the doctor (MD) even orders lab tests.
blue, gold top aka red aka SST, green, purple.
What are the 3 type of most common tubed used in hematology?
Tell me about purple tube?
How does EDTA prevent clotting?
What are some tests for hematology?
Tell me about the blue tube?
How does sodium citrate prevent clotting?
What are some tests for sodium citrate?
Tell me about he green tube?
How does the green tube prevent clotting?What are some tests the green tube is used for?
Three types of anticoagulants commonly used in Hematology
1) Purple/Lavender top:
Contains EDTA which is a chemical that binds/chelates calcium to prevent clotting
Used for most Hematology and Flow Cytometry tests:
CBC
WBC differential
RBC morphology (shape)
Flow cytometry, which is a laser‑based test that examines individual cells in a fluid sample (blood or bone marrow) to count, sort, and identify them.
T4 or T8 lymphs (immune cell markers), etc.
2) Light blue top
contains sodium citrate which binds to calcium.
Used for Coagulation tests:
PT
PTT
Fibrinogen
Anti‑Xa
D‑dimer, etc.
3) Green top:
Contains sodium or lithium heparin
which stops thrombin formation).Used for Molecular testing, such as:
PCR (DNA amplification)
FISH (genetic fluorescence testing)
Genetics, etc.
How much do micro-collection containers collect?
Do they have a vacuum?
Microcollection Containers for collecting 250-500 uL by skin puncture.
They have no vacuum
Order of draw plus whats inside
Blood Culture bottles (aerobic/anaerobic)
Syringe draw: Anaerobic → Aerobic
Vacutainer draw: Aerobic → Anaerobic
Light Blue – Sodium citrate (coagulation)
Red – No additive / clot activator
Gold / SST – Serum separator
Green – Heparin
Lavender/Purple – EDTA
Gray – Fluoride/oxalate (glucose, lactate)
What must happen after specimen collection but before leaving the patient side?
Immediately after specimen collection & before leaving the patient, the tube must be labeled with patient identification by the phlebotomist
Why must the label not obscure the view of the sample?
What must lab staff be able to see to confirm before testing?
Why should incorrect labeling or double labeling make you suspicious about the sample?
What patient identifier must be included on every specimen label?
The label must not obscure (cover or block) the view of the sample, so lab testing staff can check the sample.
They must be able to see:
Lack of hemolysis (no broken red blood cells)
Lack of clotting (no clots)
Correct specimen type before testing
Incorrect labeling or double labeling (two labels on one tube) should make you suspicious (concerned) about what else may be wrong with the sample.
Minimum specimen label information required:
Patient’s Full Name
Patient’s Medical Record Number (MRN) or Date of Birth (DOB)
Date & Time of collection
Initials of collector
Remember label on tube goes from the left
With the automation of lab tests, it's very important for what?
With the automation of lab tests, it’s very important that the specimen labels be correctly attached

Which label goes on the tube and why can’t we use the other one?
What are the small label called?
The large, top Barcode label is the one that goes on the tube.
The 2 smaller ones below the large are called Aliquot labels
These smaller Aliquot labels cannot be used to run samples through the analyzer’s bar code reader, as they are too small & don’t contain sufficient information.
What happens when too little anticoagulant is present in a tube?
Can clotting occur if anticoagulant tubes are not mixed immediately after collection?
What happens when too much anticoagulant is present in a tube?
For hematology, EDTA cannot be swapped out — each anticoagulant affects blood cells differently
Incorrect amount of anticoagulant:
Too little anticoagulant: blood partially clots → bad cell counts + bad coagulation tests.
Clotting also occurs if anticoagulant tubes are not mixed immediately after collection.
Too much anticoagulant: sample becomes diluted which gives us a falsely low results
can affect cell counts, hemoglobin concentration (Hgb), PT, PTT, fibrinogen
Define ambient temperature
What does low temperature due to vacutainer tubes?
What does high temperature due to vacutainer tubes?
What does altitude due to the drawing volume?
What does humidity due to the vacutainer tubes?
What tubes dues sunlight affect?
Ambient temperature (surrounding temperature)
Low temperatures:
Cause a decrease in the gas inside the tube (air pressure drops), which increases the draw volume (more blood gets pulled in).
High temperatures:
Cause an increase in the draw volume and can affect the integrity (strength/quality) of the additive (chemical inside the tube).
Altitude
Drawing blood at higher altitude results in lower draw volumes because the air pressure is lower (less force pulling blood in).
Humidity (moisture in the air)
High humidity in plastic tubes causes a buildup of water vapor (tiny water droplets in the air) that can affect the integrity (quality/function) of the additive.
Sunlight
Light sensitivity affects CTAD tubes.
CTAD = citric acid, theophylline, adenosine, dipyridamole
Sunlight also affects bilirubin (yellow pigment measured in Chemistry tests), causing it to break down.
What is the shelf life of Vacutainer tubes?
How long do Vacutainer tubes usually retain their vacuum after the printed expiration date?
Why can MT classes use expired Vacutainer tubes for practice?
Expiration dats
Vacutainer Tubes are good for 12 months (shelf life).
They usually keep their vacuum (suction) for 1 extra year.
MT classes use expired tubes for practice only, because the vacuum still works.
What is a blood smear, and how much blood is used to make it?
Within what time frame must a blood smear be made from EDTA whole blood and why?
Define CBC?
Within how many hours should a CBC be analyzed?
How long is a CBC sample generally stable at room temperature?
Define ESR
Within how many hours must an ESR be tested if stored at room temperature?
Within how many hours must an ESR be tested if refrigerated?
Define reticulocyte
How long are reticulocyte counts stable at room temperature?
How long are reticulocyte counts stable if refrigerated?
Can we freeze EDTA and why?
Can we expose EDTA whole blood to direct sunlight or high heat and why?
what color will the sample turn into when high temperature happens?
Storage Requirements for Hematology EDTA Whole Blood
Blood smears prepared from EDTA whole blood
Blood smear is just making a slide from the blood collected, only use a small amount
We got to make sure we make the smear within 1 hour of collection to preserve the integrity (shape + quality) of the blood cells and prevent artifact formation (fake changes that look like disease but are caused by delay).
CBC (Complete Blood Count)
CBC should be analyzed within 6 hours, but the sample is generally stable for 24 hours at room temperature (RT).
ESR (Erythrocyte Sedimentation Rate)
Erythrocyte Sedimentation Rate (ESR) or "sed rate" test measures how quickly red blood cells sink to the bottom of a test tube in one hour
Must be tested within 4 hours if stored at room temperature (RT).
Must be tested within 12 hours if refrigerated.
Reticulocyte counts
Reticulocytes are immature red blood cells (RBCs) produced in the bone marrow
Stable for up to 6 hours at room temperature (RT).
Stable for up to 72 hours if refrigerated.
Do NOT freeze EDTA whole blood
Freezing will lyse (burst/break open) all the blood cells.
Do NOT expose EDTA whole blood to direct sunlight or high heat
Avoid temperatures higher than 40°C (104°F) because heat above this level will also lyse (destroy) the blood cells and turn the sample a brownish color
Order of draw for microtainers
Order of draw prevents additive contamination.
Order of draw is for both microtainer and evacuated tube collections.
Blood gas
EDTA (lavender/pink)
Other additive mini-containers tubes (green, gray)
Serum tubes (red, gold/SST)

Regular order of draw

What percentage of blood is made up of erythrocytes (RBCs)?
What is the shape of erythrocytes (RBCs)?
Do erythrocytes have a nucleus?
What protein do erythrocytes contain that carries gases and what gases does it carry?
What percentage of blood is made up of leukocytes (WBCs)?
How much larger are leukocytes compared to RBCs?
Do leukocytes have a nucleus?
What is the function of leukocytes?
Erythrocytes / RBCs (~44%)
Biconcave disks (donut‑shaped cells with a dip in the center)
No nucleus
Contain hemoglobin (protein that carries gases)
Function: Transport O₂ (oxygen) and CO₂ (carbon dioxide) throughout the body
Leukocytes aka white blood cells (WBC) (~1%)
2–4× larger than RBCs
Have a nucleus
Function in defense against foreign antigens (invaders like bacteria, viruses, parasites)
Types of WBCs
Granulocytes (granules in cytoplasm)
Neutrophils: Fight bacterial infections
Eosinophils: Fight parasite infections and allergies
Basophils: Release histamine during allergic reactions
Non‑Granulocytes (Agranulocytes)
Lymphocytes
Responsible for cellular immunity (T‑cells attacking infected cells)
Responsible for humoral immunity (B‑cells making antibodies)
Monocytes
Perform phagocytosis (eating/engulfing) of Foreign substances and Dead or dying cells
Platelets aka Thrombocytes aka PLTs (~1%)
Much smaller than RBCs
No nucleus, not full cells since they are just fragments (pieces) of another cell
Platelets are pieces of the cytoplasm from a megakaryocyte (large bone‑marrow cell that produces platelets)
Platelets are involved in hemostasis (normal blood‑clotting process to stop bleeding).
Platelets help form a barrier (platelet plug) to limit blood loss at an injured site.
They do this by:
Sticking to the damaged vessel
Clumping together
Activating clotting factors
The Wright Stain is the most commonly used stain for blood smears.
Wright contains 2 dyes: Eosin and Methylene Blue
How cells stain
RBCs stain red
WBCs & Platelets stain various shades of blue
Neutrophil types:
bands (immature)
segmented (mature)

Eosinophil is red

Basophil
Monocyte vs lymphocyte
Monocytes are way larger and have foamy appearance for both nucleus and cytoplasm
Monocytes are the largest type of white blood cell (leukocyte)
Lymphocyte have denser nucleus and
Do Chapter 2 Review Questions 1-7 & Case Study 2.2